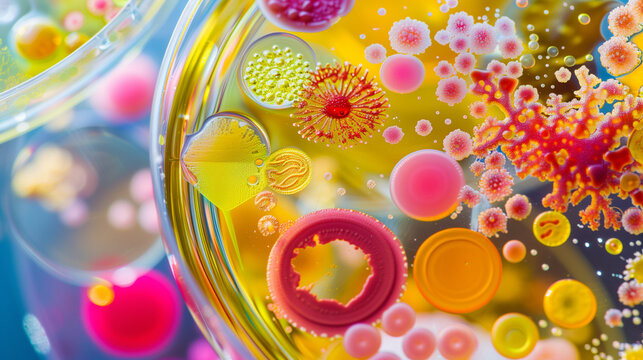

Pharmacology and Therapeutics Exams
These online examinations are designed to assess students’ understanding of core pharmacological principles and their clinical applications. The exams cover key topics, including pharmacokinetics, pharmacodynamics, routes of drug administration, adverse drug reactions, autonomic pharmacology, renal pharmacology, cardiovascular drugs, blood pharmacology, GIT, respiratory, endocrine, central nervous system, chemotherapy, immunosuppressants drugs, pharmacological agents used in urology, ophthalmology, dermatology and clinical toxicology.
The questions are structured to evaluate different cognitive levels, including knowledge recall, comprehension, and clinical reasoning, in accordance with modern medical education standards. Some questions may include clinical scenarios similar to those used in international examinations such as USMLE, requiring students to apply pharmacological knowledge in therapeutic decision-making.
Students are advised to read each question carefully and select the most appropriate answer. Ensure proper time management and submit the examination before the allocated time expires.
These examinations aims to evaluate your readiness to apply pharmacological knowledge safely and effectively in clinical practice.
We wish you success in your examination.